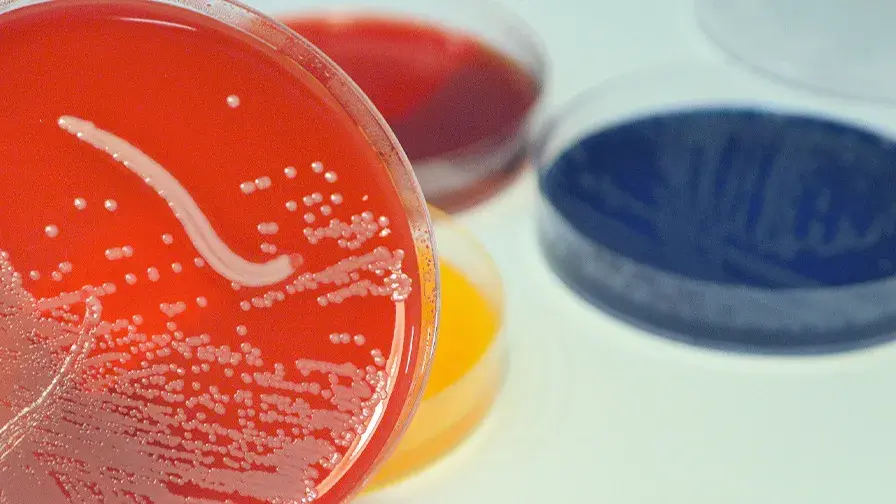
Vaincre le sepsis

Mis à jour le 10/02/2025
Le premier centre mondial pour vaincre la plus grave des infections : le sepsis
Bien que relativement méconnu du grand public, le sepsis est la complication la plus grave des infections. Il est caractérisé par une perte du contrôle de l'inflammation conduisant à l’atteinte des fonctions vitales. Selon l’Organisation mondiale de la santé (OMS), le sepsis touche chaque année 50 millions de personnes (dont 45 % d’enfants de moins de 5 ans), est responsable d’un décès sur quatre dans le monde et de handicaps psychiques et moteurs chez un survivant sur deux. L’Université Paris-Saclay, le CEA, l’AP-HP, l’Inserm et leurs partenaires académiques, associatifs et industriels, ont organisé le 17 septembre une matinée de lancement de l’Institut hospitalo-universitaire (IHU) Prometheus, premier centre mondial intégrant recherche, formation et soins pour vaincre le sepsis.
Camille Galap, président de l’Université Paris-Saclay, Nicolas Revel, directeur général de l’Assistance Publique - Hôpitaux de Paris (AP-HP), Anne-Isabelle Étienvre, directrice de la recherche fondamentale du CEA et Didier Samuel, président directeur général de l’Institut national de la santé et de la recherche médicale (Inserm) ont fait l’ouverture, mardi 17 septembre, de la matinée de lancement de l’IHU Prometheus, en présence de Sylvie Retailleau, ministre de l’enseignement supérieur et de la recherche. L’IHU Prometheus est le premier institut mondial dédié à la lutte contre le sepsis, intégrant chercheurs, chercheuses, soignantes, soignants, patients et patientes, institutions et partenaires privés, au sein d'un écosystème de prévention, soin, recherche, formation et transfert technologique.
La création de l’IHU a pour objectif de favoriser le développement de nouveaux tests diagnostiques et de nouveaux médicaments pour réduire de moitié en dix ans le fardeau sanitaire, social et économique que représente le sepsis.
C’est ce qu’ont confirmé Mervyn Singer, président du Conseil scientifique indépendant, international de l’IHU, Jamila Hedjal, présidente de France Sepsis Association et Marisol Touraine, présidente du Conseil de surveillance de l’IHU qui s’exprimaient également en introduction de la matinée.
Une triple ambition scientifique pour une médecine de précision :
. une meilleure compréhension des interactions moléculaires et cellulaires entre l’hôte et les pathogènes à l'origine de la progression de l'infection non compliquée vers le sepsis, la mise en place d’une cohorte longitudinale de 10 000 patientes et patients suivis sur 10 ans, unique au monde permettant de mieux comprendre le sepsis long et ses conséquences sociales et économiques ;
. la validation et la commercialisation d'une plateforme de tests rapides pour caractériser finement à l’échelle de chaque individu la réponse de l’hôte à l’infection et des cibles thérapeutiques et la création d'un jumeau numérique spécifique du sepsis pour anticiper précisément la réponse de chaque individu aux différents traitements ;
. le développement de nouveaux traitements tels que de petites molécules innovantes, nanomédicaments, biothérapies, vaccins et des stratégies modulant les microbiotes.

